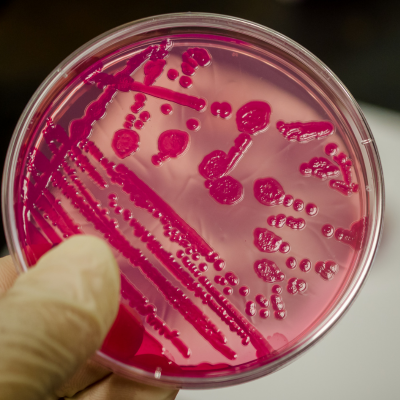

Ipari mosás? Tények, tévhitek, irányelvek, protokoll
A többször használatos poharak, akkor adnak valódi előnyt, ha az általuk ígért két előny találkozik: kevesebb hulladék és biztonságos higiénia. A kulcs az utóbbi esetében az ipari mosás. Azaz megfelelő hőfok, vegyszer, kontaktidő, alaposan dokumentált folyamat.
Mosás? Iparilag? Mit jelent ez? Mutatjuk az alábbi 3 pontban:
1. Ellenőrzött fertőtlenítő hatás
A kereskedelmi azaz az ipari környezetben használt nagyteljesítményű mosogatógépek nemcsak tisztítanak, hanem szabvány szerint fertőtlenítenek is. A National Sanitation Foundation (NSF) és az American National Standards Institute (ANSI)* közösen fejlesztett szabványai előírják, hogy az “ipari mosogatógépeknek” legalább 99,999% (5-log) baktériumcsökkenést kell elérniük, a gép típusától függően 74-82 °C-os végöblítésű hőmérsékleten. A háztartási mosogatógépek és megoldások ezt a szintet nem tudják stabilan hozni.
*Az NSF/ANSI célja olyan szabványok megalkotása, amelyek célja, a közegészség, a biztonság és a környezeti fenntarthatóság előmozdítása az ivóvíz rendszerekkel érintkezésbe kerülő termékkel kapcsolatban. Az NFS független tanúsító testületként működik; teszteli és tanúsítja a termékeket az NSF/ANSI szabványoknak megfelelően.


2. Mesterhármas
…azaz hőfok + vegyszer + idő. Nem egyetlen paraméter határozza meg a biztonságos Repohár mosást! A nemzetközi útmutatók a meghatározott hőmérséklet mellett, az ipari mosogatógépekbe beépített fertőtlenítő programok használatát javasolják. A megfelelő élelmiszeripari minőségű fertőtlenítőszerek kiválasztása kulcsfontosságú: ezek esetében mindig a gyártói előírás az irányadó! A hő és a fertőtlenítőszer csak akkor tudja kifejteni a hatását, ha elegendő ideig érintkezik a felülettel! A legtöbb irányelv 10-30 másodperc közé teszi azt a konaktidőt, ami garantálni tudja hogy a kórokozók biztonságos szintre csökkenjenek.
Nemzetközi és európai irányelvek, amelyek a „mesterhármas” szemléletet írják elő:
- WHO – Food Safety: Five Keys to Safer Food
- EU Food Safety & Hygiene Regulations (EC 852/2004)
- FDA Food Code (2022)
- CDC – Cleaning & Sanitizing Food Contact Surfaces
- NSF / ANSI Standard 3 -Commercial Warewashing Equipment
- EFCI – European Federation for Cleaning Industries
3. Védelem a (tipikus) kórokozók ellen
A rendezvény környezetben nem a kosz a legfőbb ellenség, hanem az olyan fertőző ágensek, amelyek nagyon kis dózisban is megbetegítenek, mint a norovírus, az E. coli, a salmonella, vagy a listeria. A higiénés protokollok: kézhigiénia, felülettisztítás, szanitáció betartása és rendszeres alkalmazása a megelőzés kulcsa. Ehhez természetesen nélkülözhetetlen a szabványosított, magas hőfokú ciklikus mosás és a szigorú személyzeti fegyelem.
Tények és tévhitek:
Amit tudunk:
- Anyag: a Repohár élelmiszeripari polipropilén. Nem porózus, nem veszi át tartósan a szagokat, ipari mosásra tervezett.
- Technológia: az IML-technológiával készült grafika tartósan beépül az anyagba, mosásálló. A szitanyomás is tartós megfelelő hőfokú mosás és gyakoriság mellett!
- Biztonság: az ipari mosás standardizáltan biztosítja a mikrobiológiai kockázatok csökkenését.
- Zónázás: a szigorúan szeparált tiszta és használt Repoharak csökkentik az átszennyeződés lehetőségét, biztosítják a mosási előnyöket.
Amit gyakran hallunk:
- “Elég a kézi mosás!”: Nem, nem elég! Ahhoz, hogy biztonságos és streill Repoharak kerüljenek a vendégek kezébe a kézzel való elmosás nem elegendő. A hőfok-vegyszer-idő hármasának bármelyik hiánya gyenge pontként jelenik meg a biztonság szempontjából.
- “Jó lesz a forró víz is.” A gyakorlat és a különböző vizsgálatok azt mutatják, hogy nem. A biofilmek és vírusok ellen mindenképp kombinált hatás kell. Ennek hiányában maradhatnak életképes kórokozók.
- “A minta kopik mosásnál.” Az IML-technológia teljesen a pohár részévé válik, ami bírja az ipari mosást. A szitanyomott újra poharak esetében a gyártói mosási tartomány biztosít tartósságot.
- “Töröljünk, az gyorsabb”. A törlőkendővel vagy más törlésre alkalmas textíliák alkalmazásával könnyen alakíthatunk ki keresztszennyezést. Az ipari gyakorlat az állványon történő levegős szárítást alkalmazza, ahol csak a teljesen száraz Repoharak kerülhetnek be a zárt dobozba.
A 2 leggyakoribb hiba a fentiek alapján +1, azaz így ne csináld, ha vendéhlátóhelyként vagy catering szolgáltatóként alkalmazod a Repoharat?
- Otthoni mosogatógép használata nagy mennyiségben: nem standardizált a hőfok – vegyszer-idő hármasa, nagy esély a ferzősek kialakulására
- A többször használatos műanyag poharak nedvesen kerülnek be a dobozba: a pára a mikrobiológiai kockázatok jó barátja. A barátság részleteit nem kell újra bemutatnunk.
+1) Zónakeverés: használt és tiszta Repoharak együttes használata. A logisztikai fegyelem és következetesség hiánya.
A Repoharak biztonságos mosássa nem ígéret, hanem eljárás. Szabványos ipari mosás, szigorú zónázás, szárítás és dokumentálás. A körforgás csak így lesz biztonságos!
Bízd ránk a többször használatos Repoharak ipari mosását és mi garantáljuk a zöld működést!

